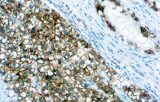
PLAP

La inmunohistoquímica (IHQ) se ha convertido en un componente esencial de la patología genitourinaria (GU) moderna, permitiendo la caracterización precisa de tumores que afectan a la próstata, riñón, vejiga urinaria y testículo. La literatura revisada por pares destaca consistentemente que la morfología sola puede ser insuficiente en biopsias difíciles o muestras de tejido limitadas; por lo tanto, los paneles de IHQ basados en anticuerpos desempeñan un papel central en el diagnóstico diferencial, la clasificación tumoral y la toma de decisiones clínicas guiadas por biomarcadores.
Los anticuerpos validados CE/IVD diseñados para flujos de trabajo diagnósticos de IHQ se utilizan ampliamente para apoyar protocolos de tinción estandarizados y reproducibles en laboratorios clínicos. Estos reactivos son particularmente relevantes para laboratorios de patología que operan en entornos diagnósticos regulados donde se requiere fiabilidad analítica y cumplimiento normativo. Desde una perspectiva científica, la IHQ funciona como complemento a la histomorfología al resaltar proteínas específicas de linaje, marcadores de diferenciación celular y antígenos tumorales asociados que definen las neoplasias genitourinarias.
Características clave de los anticuerpos CE/IVD para IHQ en patología GU
Alta especificidad y sensibilidad diagnóstica
Los datos revisados por pares demuestran que los marcadores de anticuerpos seleccionados proporcionan una fuerte discriminación diagnóstica, mejorando la precisión en casos difíciles donde la histología rutinaria sola puede ser inconclusa.
Estandarización para laboratorios clínicos
Los anticuerpos CE/IVD apoyan flujos de trabajo de tinción e interpretación estandarizados, alineándose con prácticas diagnósticas guiadas por guías descritas en revisiones de patología genitourinaria.
Apoyo al diagnóstico diferencial
Los paneles de IHQ permiten diferenciar entre mimetizadores benignos, tumores GU primarios y malignidades metastásicas mediante el resaltado de linaje celular y antígenos tumorales específicos.
Integración en la oncología moderna guiada por biomarcadores
La literatura reciente destaca el papel creciente de la IHQ como sustituto del perfilado molecular y el descubrimiento de biomarcadores, particularmente en la subtipificación del cáncer de vejiga y próstata.